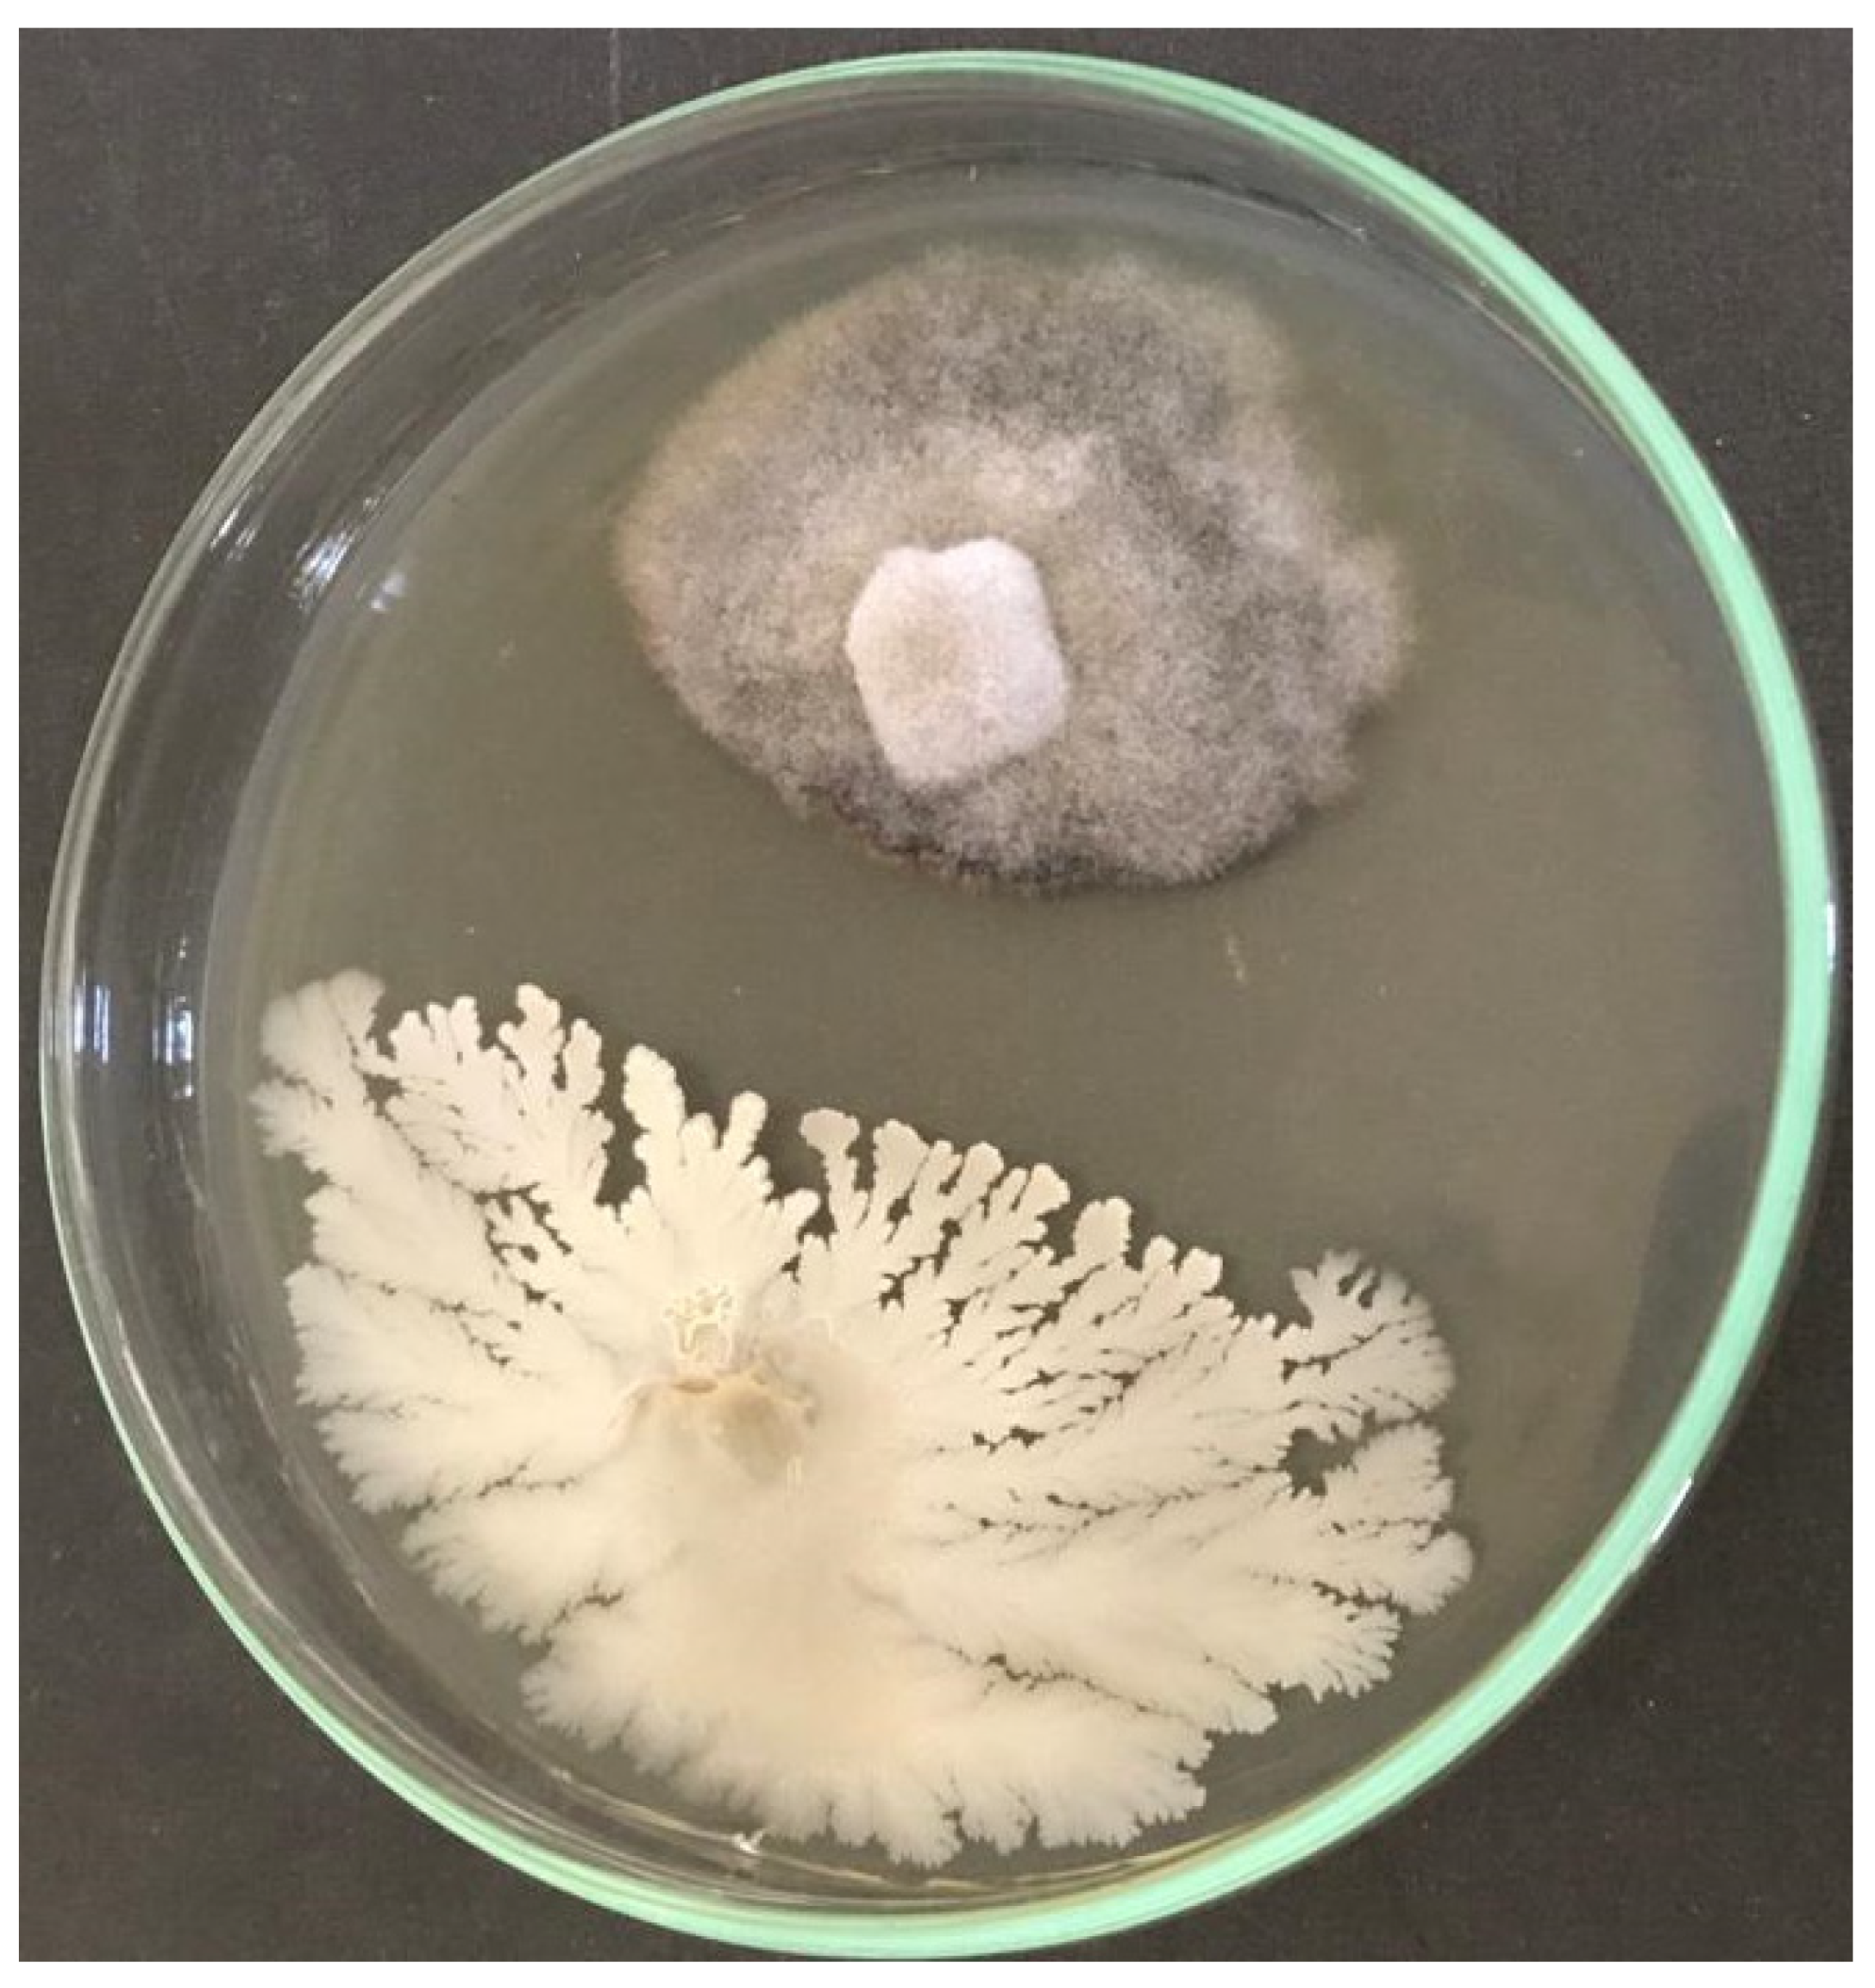
Micromachines 13 01423 g001
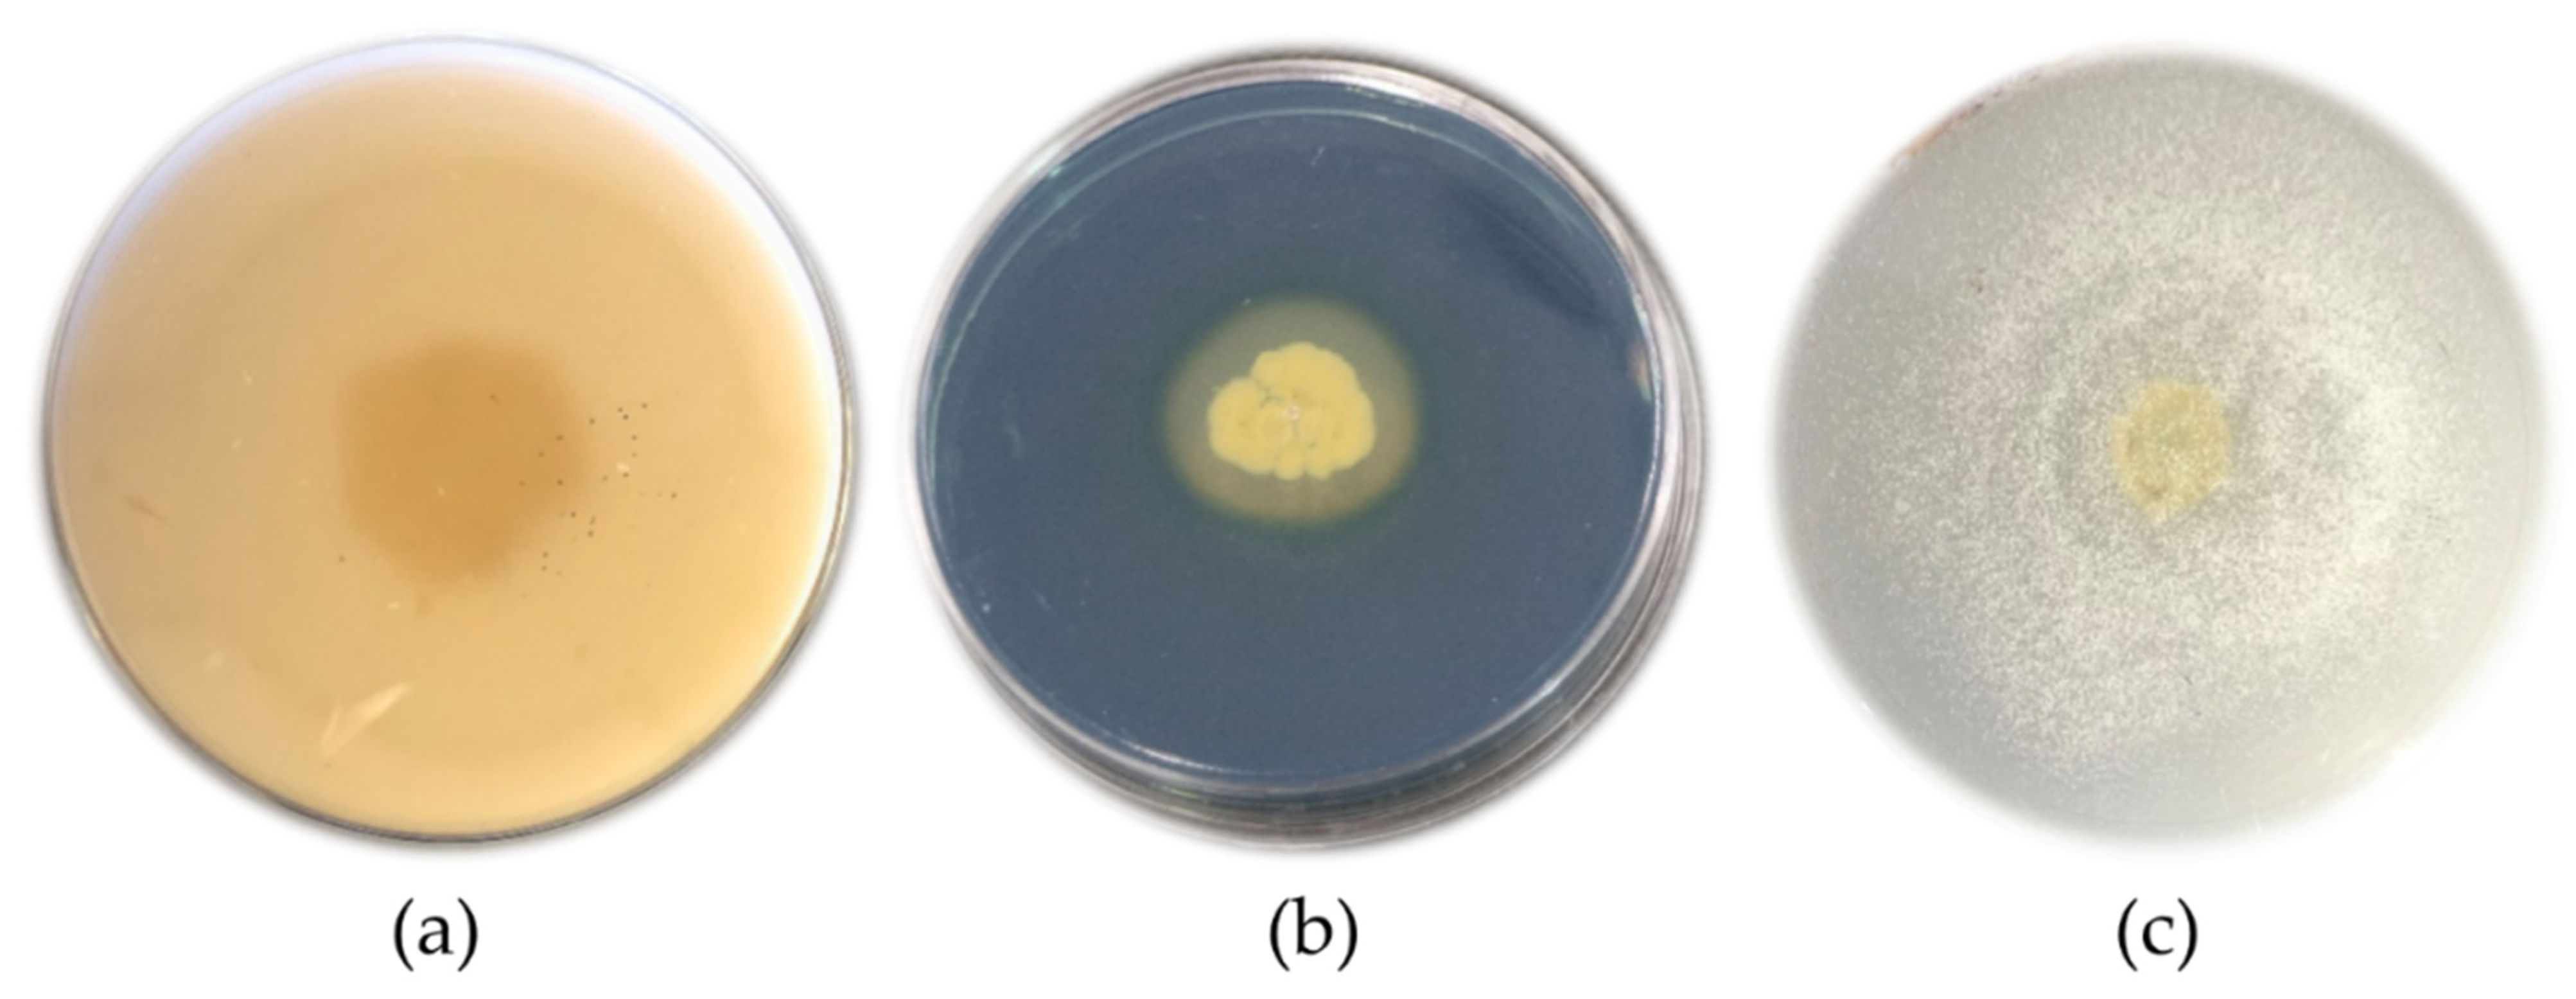
Micromachines 13 01423 g002

Microencapsulation of Bacillus velezensis Using Alginate-Gum Polymers Enriched with TiO2 and SiO2 Nanoparticles
Abstract
:1. Introduction
2. Materials and Methods
2.1. Preparation of Antagonist Bacteria and Pathogen
2.2. In Vitro Evaluation of the Antifungal Activity of Bacillus velezensis against Gaeumannomyces graminis var. tritici
2.3. Evaluation of Bacillus velezensis to Produce Antifungal and PGPR Metabolites
2.3.1. Protease Enzyme
2.3.2. Lipase Enzyme
2.3.3. Indole-3-Acetic Acid
2.3.4. Siderophore
2.3.5. Evaluation of the Phosphate Mineral Solubility
2.4. Preparation of Bacterial Microcapsules and Study of Their Properties
2.4.1. Materials Utilized in Microcapsule Production
2.4.2. Synthesis of TiO2 NPs
2.4.3. Synthesis of SiO2 NPs
2.4.4. Characterization of NPs
2.4.5. Evaluating the Antibacterial Activity of Nanoparticles and Natural Gums
2.4.6. Preparation of Bacterial Cell Culture
2.4.7. Preparation of Microcapsules
2.5. Instrumental Characterization of Microcapsules
2.5.1. SEM Analyses
2.5.2. FTIR Analyses
2.5.3. XRD Analyses
2.6. Moisture Content of Microcapsules
2.7. Swelling Ratio of Microcapsules
2.8. Encapsulation Efficiency
2.9. Evaluation of Bacterial Release from Microcapsules
2.10. Statistical Analysis
3. Results
3.1. In Vitro Evaluation of the Antifungal Activity of Bacillus velezensis against Gaeumannomyces graminis var. tritici
3.2. Evaluation of Bacillus velezensis to Produce Some Metabolites
3.3. Characterization of SiO2 and TiO2 NPs
3.4. Evaluating the Antibacterial Activity of Nanoparticles and Natural Gums
3.5. Instrumental Characterization of Microcapsules
3.5.1. SEM Analyses
3.5.2. FTIR Analyses
3.5.3. XRD Analyses
3.6. Moisture Content and Swelling Ratio of Microcapsules
3.7. Encapsulation Efficiency
3.8. Evaluation of Bacterial Release from Microcapsules
4. Discussion
5. Conclusions
Author Contributions
Funding
Conflicts of Interest
References
- Fathi, F.; Saberi-Riseh, R.; Khodaygan, P. Survivability and controlled release of alginate-microencapsulated Pseudomonas fluorescens VUPF506 and their effects on biocontrol of Rhizoctonia solani on potato. Int. J. Biol. Macromol. 2021, 183, 627–634. [Google Scholar] [CrossRef]
- Hassanisaadi, M.; Shahidi Bonjar, G.H.; Hosseinipour, A.; Abdolshahi, R.; Ait Barka, E.; Saadoun, I. Biological control of Pythium aphanidermatum, the causal agent of tomato root rot by two Streptomyces root symbionts. Agronomy 2021, 11, 846. [Google Scholar] [CrossRef]
- Olanrewaju, O.S.; Glick, B.R.; Babalola, O.O. Mechanisms of action of plant growth promoting bacteria. World J. Microbiol. Biotechnol. 2017, 33, 197. [Google Scholar] [CrossRef] [PubMed]
- Vejan, P.; Abdullah, R.; Khadiran, T.; Ismail, S.; Nasrulhaq Boyce, A. Role of plant growth promoting rhizobacteria in agricultural sustainability—A review. Molecules 2016, 21, 573. [Google Scholar] [CrossRef] [PubMed]
- Fan, B.; Wang, C.; Song, X.; Ding, X.; Wu, L.; Wu, H.; Gao, X.; Borriss, R. Bacillus velezensis FZB42 in 2018: The gram-positive model strain for plant growth promotion and biocontrol. Front. Microbiol. 2018, 9, 2491. [Google Scholar] [CrossRef] [PubMed]
- Saberi-Riseh, R.; Moradi-Pour, M. A novel encapsulation of Streptomyces fulvissimus Uts22 by spray drying and its biocontrol efficiency against Gaeumannomyces graminis, the causal agent of take-all disease in wheat. Pest Manag. Sci. 2021, 77, 4357–4364. [Google Scholar] [CrossRef] [PubMed]
- Saberi Riseh, R.; Skorik, Y.A.; Thakur, V.K.; Moradi Pour, M.; Tamanadar, E.; Noghabi, S.S. Encapsulation of plant biocontrol bacteria with alginate as a main polymer material. Int. J. Mol. Sci. 2021, 22, 11165. [Google Scholar] [CrossRef]
- Moradi-Pour, M.; Saberi-Riseh, R.; Esmaeilzadeh-Salestani, K.; Mohammadinejad, R.; Loit, E. Evaluation of Bacillus velezensis for biological control of rhizoctonia solani in bean by alginate/gelatin encapsulation supplemented with nanoparticles. J. Microbiol. Biotechnol. 2021, 13, 1373–1382. [Google Scholar] [CrossRef]
- Moradi Pour, M.; Saberi Riseh, R.; Skorik, Y.A. Sodium Alginate–Gelatin Nanoformulations for Encapsulation of Bacillus velezensis and Their Use for Biological Control of Pistachio Gummosis. Materials 2022, 15, 2114. [Google Scholar] [CrossRef]
- Nedovic, V.; Kalusevic, A.; Manojlovic, V.; Levic, S.; Bugarski, B. An overview of encapsulation technologies for food applications. Procedia Food Sci. 2011, 1, 1806–1815. [Google Scholar] [CrossRef] [Green Version]
- Wang, Y.; Wu, H.; Wang, Z.; Zhang, J.; Zhu, J.; Ma, Y.; Yang, Z.; Yuan, Y. Optimized synthesis of biodegradable elastomer pegylated poly (glycerol sebacate) and their biomedical application. Polymers 2019, 11, 965. [Google Scholar] [CrossRef] [PubMed]
- Mani, G.; Feldman, M.D.; Patel, D.; Agrawal, C.M. Coronary stents: A materials perspective. Biomaterials 2007, 28, 1689–1710. [Google Scholar] [CrossRef] [PubMed]
- Dobrinčić, A.; Balbino, S.; Zorić, Z.; Pedisić, S.; Bursać Kovačević, D.; Elez Garofulić, I.; Dragović-Uzelac, V. Advanced technologies for the extraction of marine brown algal polysaccharides. Mar. Drugs 2020, 18, 168. [Google Scholar] [CrossRef] [PubMed]
- dos Santos Silva, M.; Cocenza, D.S.; Grillo, R.; de Melo, N.F.S.; Tonello, P.S.; de Oliveira, L.C.; Cassimiro, D.L.; Rosa, A.H.; Fraceto, L.F. Paraquat-loaded alginate/chitosan nanoparticles: Preparation, characterization and soil sorption studies. J. Hazard. Mater. 2011, 190, 366–374. [Google Scholar] [CrossRef]
- Saberi-Rise, R.; Moradi-Pour, M. The effect of Bacillus subtilis Vru1 encapsulated in alginate–bentonite coating enriched with titanium nanoparticles against Rhizoctonia solani on bean. Int. J. Biol. Macromol. 2020, 152, 1089–1097. [Google Scholar] [CrossRef]
- MoradiPour, M.; Saberi-Riseh, R.; Mohammadinejad, R.; Hosseini, A. Investigating the formulation of alginate-gelatin encapsulated Pseudomonas fluorescens (VUPF5 and T17-4 strains) for controlling Fusarium solani on potato. Int. J. Biol. Macromol. 2019, 133, 603–613. [Google Scholar]
- Fathi, F.; Saberi Riseh, R.; Khodaygan, P.; Hosseini, S.; Skorik, Y.A. Microencapsulation of a Pseudomonas Strain (VUPF506) in Alginate–Whey Protein–Carbon Nanotubes and Next-Generation Sequencing Identification of This Strain. Polymers 2021, 13, 4269. [Google Scholar] [CrossRef]
- Tu, L.; He, Y.; Yang, H.; Wu, Z.; Yi, L. Preparation and characterization of alginate–gelatin microencapsulated Bacillus subtilis SL-13 by emulsification/internal gelation. Plant Physiol. Biochem. 2015, 26, 735–749. [Google Scholar]
- Smithers, G.W. Whey and whey proteins—From ‘gutter-to-gold’. Int. Dairy J. 2008, 18, 695–704. [Google Scholar] [CrossRef]
- Taghavizadeh Yazdi, M.E.; Nazarnezhad, S.; Mousavi, S.H.; Sadegh Amiri, M.; Darroudi, M.; Baino, F.; Kargozar, S. Gum tragacanth (GT): A versatile biocompatible material beyond borders. Molecules 2021, 26, 1510. [Google Scholar] [CrossRef]
- Fadavi, G.; Mohammadifar, M.A.; Zargarran, A.; Mortazavian, A.M.; Komeili, R. Composition and physicochemical properties of Zedo gum exudates from Amygdalus scoparia. Carbohydr. Polym. 2014, 101, 1074–1080. [Google Scholar] [CrossRef] [PubMed]
- Hassanisaadi, M.; Barani, M.; Rahdar, A.; Heidary, M.; Thysiadou, A.; Kyzas, G.Z. Role of agrochemical-based nanomaterials in plants: Biotic and abiotic stress with germination improvement of seeds. Plant Growth Regul. 2022, 97, 375–418. [Google Scholar] [CrossRef]
- Okey-Onyesolu, C.F.; Hassanisaadi, M.; Bilal, M.; Barani, M.; Rahdar, A.; Iqbal, J.; Kyzas, G.Z. Nanomaterials as nanofertilizers and nanopesticides: An overview. ChemistrySelect 2021, 6, 8645–8663. [Google Scholar] [CrossRef]
- Chowdappa, P.; Gowda, S. Nanotechnology in crop protection: Status and scope. Pest Manag. Hortic. Ecosyst. 2013, 19, 131–151. [Google Scholar]
- Park, M.R.; Banks, M.K.; Applegate, B.; Webster, T.J. Influence of nanophase titania topography on bacterial attachment and metabolism. Int. J. Nanomed. 2008, 3, 497. [Google Scholar]
- Fincheira, P.; Rubilar, O.; Espinoza, J.; Aniñir, W.; Méndez, L.; Seabra, A.B.; Quiroz, A. Formulation of a controlled-release delivery carrier for volatile organic compounds using multilayer O/W emulsions to plant growth. Colloids Surf. A Physicochem. Eng. Asp. 2019, 580, 123738. [Google Scholar] [CrossRef]
- McSpadden Gardener, B.; Schroeder, K.; Kalloger, S.; Raaijmakers, J.; Thomashow, L.; Weller, D. Genotypic and phenotypic diversity of phlD-containing Pseudomonas strains isolated from the rhizosphere of wheat. Appl. Environ. Microbiol. 2000, 66, 1939–1946. [Google Scholar] [CrossRef]
- Thomashow, L.S.; Weller, D.M. Role of a phenazine antibiotic from Pseudomonas fluorescens in biological control of Gaeumannomyces graminis var. tritici. J. Bacteriol. 1988, 170, 3499–3508. [Google Scholar] [CrossRef]
- Maurhofer, M.; Keel, C.; Haas, D.; Défago, G. Influence of plant species on disease suppression by Pseudomonas fluorescens strain CHAO with enhanced antibiotic production. Plant Pathol. 1995, 44, 40–50. [Google Scholar] [CrossRef]
- Sierra, G. A simple method for the detection of lipolytic activity of micro-organisms and some observations on the influence of the contact between cells and fatty substrates. Antonie Leeuwenhoek 1957, 23, 15–22. [Google Scholar] [CrossRef]
- Patten, C.L.; Glick, B.R. Role of Pseudomonas putida indoleacetic acid in development of the host plant root system. Appl. Environ. Microbiol. 2002, 68, 3795–3801. [Google Scholar] [CrossRef] [PubMed]
- Alexander, D.; Zuberer, D. Use of chrome azurol S reagents to evaluate siderophore production by rhizosphere bacteria. Biol. Fertil. Soils 1991, 12, 39–45. [Google Scholar] [CrossRef]
- Nagaraju, G.; Manjunath, K.; Ravishankar, T.; Ravikumar, B.; Nagabhushan, H.; Ebeling, G.; Dupont, J. Ionic liquid-assisted hydrothermal synthesis of TiO2 nanoparticles and its application in photocatalysis. J. Mater. Sci. 2013, 48, 8420–8426. [Google Scholar] [CrossRef]
- Zulfiqar, U.; Subhani, T.; Wilayat Husain, S. Synthesis of silica nanoparticles from sodium silicate under alkaline conditions. J. Solgel. Sci. Technol. 2016, 77, 753–758. [Google Scholar] [CrossRef]
- Rajeshkumar, S.; Malarkodi, C. In vitro antibacterial activity and mechanism of silver nanoparticles against foodborne pathogens. Bioinorg. Chem. Appl. 2014, 2014, 581890. [Google Scholar] [CrossRef]
- He, Y.; Wu, Z.; Ye, B.-C.; Wang, J.; Guan, X.; Zhang, J. Viability evaluation of alginate-encapsulated Pseudomonas putida Rs-198 under simulated salt-stress conditions and its effect on cottonágrowth. Eur. J. Soil Biol. 2016, 75, 135–141. [Google Scholar] [CrossRef]
- Wu, Z.; Guo, L.; Qin, S.; Li, C. Encapsulation of R. planticola Rs-2 from alginate-starch-bentonite and its controlled release and swelling behavior under simulated soil conditions. J. Ind. Microbiol. Biotechnol. 2012, 39, 317–327. [Google Scholar] [CrossRef]
- Alvarez-Román, R.; Barre, G.; Guy, R.H.; Fessi, H. Biodegradable polymer nanocapsules containing a sunscreen agent: Preparation and photoprotection. Eur. J. Pharm. Biopharm. 2001, 52, 191–195. [Google Scholar] [CrossRef]
- Kloepper, J.; Gutierrez-Estrada, A.; McInroy, J. Photoperiod regulates elicitation of growth promotion but not induced resistance by plant growth-promoting rhizobacteria. Can. J. Microbiol. 2007, 53, 159–167. [Google Scholar] [CrossRef]
- Ba-Abbad, M.M.; Kadhum, A.A.H.; Mohamad, A.B.; Takriff, M.S.; Sopian, K. Synthesis and catalytic activity of TiO2 nanoparticles for photochemical oxidation of concentrated chlorophenols under direct solar radiation. Int. J. Electrochem. Sci 2012, 7, 4871–4888. [Google Scholar]
- Antić, Ž.; Krsmanović, R.M.; Nikolić, M.G.; Marinović-Cincović, M.; Mitrić, M.; Polizzi, S.; Dramićanin, M.D. Multisite luminescence of rare earth doped TiO2 anatase nanoparticles. Mater. Chem. Phys. 2012, 135, 1064–1069. [Google Scholar] [CrossRef]
- Gupta, M.; Singh, D.; Singh, S.P.; Mathur, A.; Wadhwa, S.; Jaiswal, A.K.; Singh, D.K.; Yadav, R. Ultrasonic and thermophysical studies of ethylene glycol nanofluids containing TiO2 nanoparticles and their heat transfer enhancements. Johns. Matthey Technol. Rev. 2021, 65, 418–430. [Google Scholar] [CrossRef]
- Varshneya, R.; Bhadauriaa, S.; S Gaur, M. Biogenic synthesis of silver nanocubes and nanorods using sundried Stevia rebaudiana leaves. Adv. Mater. Lett. 2010, 1, 232–237. [Google Scholar] [CrossRef]
- Belščak-Cvitanović, A.; Komes, D.; Karlović, S.; Djaković, S.; Špoljarić, I.; Mršić, G.; Ježek, D. Improving the controlled delivery formulations of caffeine in alginate hydrogel beads combined with pectin, carrageenan, chitosan and psyllium. Food Chem. 2015, 167, 378–386. [Google Scholar] [CrossRef]
- Rather, S.A.; Akhter, R.; Masoodi, F.; Gani, A.; Wani, S. Effect of double alginate microencapsulation on in vitro digestibility and thermal tolerance of Lactobacillus plantarum NCDC201 and L. casei NCDC297. LWT-Food Sci. Technol. 2017, 83, 50–58. [Google Scholar] [CrossRef]
- Ramos, P.E.; Silva, P.; Alario, M.M.; Pastrana, L.M.; Teixeira, J.A.; Cerqueira, M.A.; Vicente, A.A. Effect of alginate molecular weight and M/G ratio in beads properties foreseeing the protection of probiotics. Food Hydrocoll. 2018, 77, 8–16. [Google Scholar] [CrossRef]
- Mohammadi, N.; Ehsani, M.R.; Bakhoda, H. Development of caffeine-encapsulated alginate-based matrix combined with different natural biopolymers, and evaluation of release in simulated mouth conditions. Flavour Fragr. J. 2018, 33, 357–366. [Google Scholar] [CrossRef]
- Bergo, P.; Sobral, P. Effects of plasticizer on physical properties of pigskin gelatin films. Food Hydrocoll. 2007, 21, 1285–1289. [Google Scholar] [CrossRef]
- Çabuk, B.; Harsa, Ş.T. Protection of Lactobacillus acidophilus NRRL-B 4495 under in vitro gastrointestinal conditions with whey protein/pullulan microcapsules. J. Biosci. Bioeng. 2015, 120, 650–656. [Google Scholar] [CrossRef]
- Villarreal-Delgado, M.F.; Villa-Rodríguez, E.D.; Cira-Chávez, L.A.; Estrada-Alvarado, M.I.; Parra-Cota, F.I.; Santos-Villalobos, S.D.L. The genus Bacillus as a biological control agent and its implications in the agricultural biosecurity. Rev. Mex. Fitopatol. 2018, 36, 95–130. [Google Scholar]
- Wallace, R.L.; Hirkala, D.L.; Nelson, L.M. Postharvest biological control of blue mold of apple by Pseudomonas fluorescens during commercial storage and potential modes of action. Postharvest Biol. Technol. 2017, 133, 1–11. [Google Scholar]
- Le Cocq, K.; Gurr, S.J.; Hirsch, P.R.; Mauchline, T.H. Exploitation of endophytes for sustainable agricultural intensification. Mol. Plant Pathol. 2017, 18, 469–473. [Google Scholar] [PubMed]
- Han, J.; Sun, L.; Dong, X.; Cai, Z.; Sun, X.; Yang, H.; Wang, Y.; Song, W. Characterization of a novel plant growth-promoting bacteria strain Delftia tsuruhatensis HR4 both as a diazotroph and a potential biocontrol agent against various plant pathogens. Syst. Appl. Microbiol. 2005, 28, 66–76. [Google Scholar]
- Bosmans, L.; De Bruijn, I.; De Mot, R.; Rediers, H.; Lievens, B. Agar composition affects in vitro screening of biocontrol activity of antagonistic microorganisms. J. Microbiol. Methods 2016, 127, 7–9. [Google Scholar]
- Hariprasad, P.; Niranjana, S. Isolation and characterization of phosphate solubilizing rhizobacteria to improve plant health of tomato. Plant Soil 2009, 316, 13–24. [Google Scholar]
- Lestari, P.; Suryadi, Y.; Susilowati, D.N.; Priyatno, T.P.; Samudra, I.M. Karakterisasi bakteri penghasil asam indol asetat dan pengaruhnya terhadap vigor benih padi. Ber. Biol. 2015, 14, 19–28. [Google Scholar]
- Bashan, Y.; de-Bashan, L.E.; Prabhu, S.; Hernandez, J.-P. Advances in plant growth-promoting bacterial inoculant technology: Formulations and practical perspectives (1998–2013). Plant Soil 2014, 378, 1–33. [Google Scholar]
- Bhattacharyya, P.N.; Jha, D.K. Plant growth-promoting rhizobacteria (PGPR): Emergence in agriculture. World J. Microbiol. Biotechnol. 2012, 28, 1327–1350. [Google Scholar]
- Dayamani, K.; Brahmaprakash, G. Influence of form and concentration of the osmolytes in liquid inoculants formulations of plant growth promoting bacteria. Int. J. Sci. Res. Publ. 2014, 4, 449. [Google Scholar]
- Gomez, M.; Silva, N.; Hartmann, A.; Sagardoy, M.; Catroux, G. Evaluation of commercial soybean inoculants from Argentina. World J. Microbiol. Biotechnol. 1997, 13, 167–173. [Google Scholar]
- Fernández-Chapa, D.; Ramírez-Villalobos, J.; Galán-Wong, L. Toxic potential of Bacillus thuringiensis: An overview. In Protecting Rice Grains in the Post-Genomic Era; Intech Open: London, UK, 2019. [Google Scholar]
- Lee, Y.; Ji, Y.R.; Lee, S.; Choi, M.-J.; Cho, Y. Microencapsulation of probiotic Lactobacillus acidophilus kbl409 by extrusion technology to enhance survival under simulated intestinal and freeze-drying conditions. J. Microbiol. Biotechnol. 2019, 29, 721–730. [Google Scholar] [PubMed]
- Dekkers, L.C.; Mulders, I.H.; Phoelich, C.C.; Chin-A-Woeng, T.F.; Wijfjes, A.H.; Lugtenberg, B.J. The sss colonization gene of the tomato—Fusarium oxysporum f. sp. radicis-lycopersici biocontrol strain Pseudomonas fluorescens WCS365 can improve root colonization of other wild-type Pseudomonas spp. bacteria. Plant Microbe Interact. 2000, 13, 1177–1183. [Google Scholar]
- Tripathi, D.K.; Singh, S.; Singh, V.P.; Prasad, S.M.; Dubey, N.K.; Chauhan, D.K. Silicon nanoparticles more effectively alleviated UV-B stress than silicon in wheat (Triticum aestivum) seedlings. Plant Physiol. Biochem. 2017, 110, 70–81. [Google Scholar] [PubMed]

| Treatments | Swelling Ratio % | Moisture Content % | Encapsulation Efficiency % |
|---|---|---|---|
| Alg-ZG-WPC | 123.333 ± 1.452 a | 75.820 ± 0.320 a | 94.333 ± 0.881 a |
| Alg-ZG | 118.667 ± 0.881 ab | 70.246 ± 0.301 b | 92.333 ± 0.333 a |
| Alg-WPC | 116.667 ± 0.881 ab | 68.330 ± 0.766 bc | 91.000 ± 0.577 a |
| Alg-MG-ZG | 113.000 ± 1.527 b | 66.120 ± 0.069 c | 85.667 ± 0.881 b |
| Alg-MG | 105.667 ± 2.603 c | 57.380 ± 0.643 d | 70.667 ± 1.201 c |
| Alg-TG | 101.667 ± 0.666 c | 54.176 ± 0.595 e | 67.667 ± 1.452 c |
Publisher’s Note: MDPI stays neutral with regard to jurisdictional claims in published maps and institutional affiliations. |
© 2022 by the authors. Licensee MDPI, Basel, Switzerland. This article is an open access article distributed under the terms and conditions of the Creative Commons Attribution (CC BY) license (https://creativecommons.org/licenses/by/4.0/).
Share and Cite
Pour, M.M.; Riseh, R.S.; Ranjbar-Karimi, R.; Hassanisaadi, M.; Rahdar, A.; Baino, F. Microencapsulation of Bacillus velezensis Using Alginate-Gum Polymers Enriched with TiO2 and SiO2 Nanoparticles. Micromachines 2022, 13, 1423. https://doi.org/10.3390/mi13091423
Pour MM, Riseh RS, Ranjbar-Karimi R, Hassanisaadi M, Rahdar A, Baino F. Microencapsulation of Bacillus velezensis Using Alginate-Gum Polymers Enriched with TiO2 and SiO2 Nanoparticles. Micromachines. 2022; 13(9):1423. https://doi.org/10.3390/mi13091423
Chicago/Turabian StylePour, Mojde Moradi, Roohallah Saberi Riseh, Reza Ranjbar-Karimi, Mohadeseh Hassanisaadi, Abbas Rahdar, and Francesco Baino. 2022. "Microencapsulation of Bacillus velezensis Using Alginate-Gum Polymers Enriched with TiO2 and SiO2 Nanoparticles" Micromachines 13, no. 9: 1423. https://doi.org/10.3390/mi13091423
APA StylePour, M. M., Riseh, R. S., Ranjbar-Karimi, R., Hassanisaadi, M., Rahdar, A., & Baino, F. (2022). Microencapsulation of Bacillus velezensis Using Alginate-Gum Polymers Enriched with TiO2 and SiO2 Nanoparticles. Micromachines, 13(9), 1423. https://doi.org/10.3390/mi13091423

